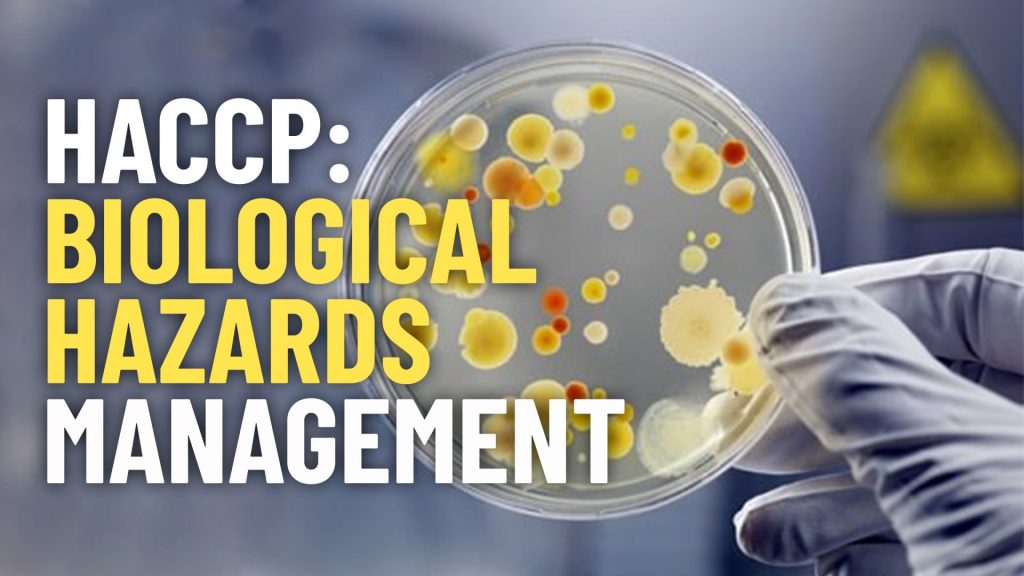

HACCP: Physical Hazards Management

Identifying and Controlling Potential Physical Hazards
HACCP: Chemical Hazards Management

Identifying and Controlling Potential Chemical Hazards
HACCP: Biological Hazards Management
Identifying and Controlling Potential Biological Hazards
HACCP: Allergen Hazards Management

Identifying and Controlling Potential Allergen Hazards
HACCP

Applying Codex HACCP Concepts for the Identification and Control of Potential Hazards
Good Manufacturing Practices

Developing, Implementing and Monitoring Good Manufacturing Practices Concepts
Good Laboratory Practices

Developing, Implementing and Monitoring Good Laboratory Practices Concepts
Good Housekeeping Practices

Developing, Implementing and Monitoring Good Housekeeping Practices Concepts
Food Safety Management

Application and Management of Food Safety Concepts
Food Retail Standards

Implementation and Management of Food Retail Standards